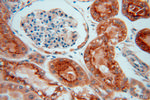
GALNS Antibody in Immunohistochemistry (Paraffin) (IHC (P))

Search
Proteintech
GALNS Polyclonal Antibody
{{$productOrderCtrl.translations['antibody.pdp.commerceCard.promotion.promotions']}}
{{$productOrderCtrl.translations['antibody.pdp.commerceCard.promotion.viewpromo']}}
{{$productOrderCtrl.translations['antibody.pdp.commerceCard.promotion.promocode']}}: {{promo.promoCode}} {{promo.promoTitle}} {{promo.promoDescription}}. {{$productOrderCtrl.translations['antibody.pdp.commerceCard.promotion.learnmore']}}
产品信息
14933-1-AP
种属反应
宿主/亚型
分类
类型
抗原
偶联物
形式
浓度
规格
纯化类型
保存液
内含物
保存条件
运输条件
产品详细信息
Immunogen sequence: ARPNIPVYR DWEMVGRYYE EFPINLKTGE ANLTQIYLQE ALDFIKRQAR HHPFFLYWAV DATHAPVYAS KPFLGTSQRG RYGDAVREID DSIGKILELL QDLHVADNTF VFFTSDNGAA LISAPEQGGS NGPFLCGKQT TFEGGMREPA LAWWPGHVTA GQVSHQLGSI MDLFTTSLAL AGLTPPSDRA IDGLNLLPTL LQGRLMDRPI FYYRGDTLMA ATLGQHKAHF WTWTNSWENF RQGIDFCPGQ NVSGVTTHNL EDHTKLPLIF HLGRDPGERF PLSFASAEYQ EALSRITSVV QQHQEALVPA QPQLNVCNWA VMNWAPPGCE KLGKCLTPPE SIPKKCLWSH (174-522 aa encoded by BC050684)
靶标信息
This gene encodes N-acetylgalactosamine-6-sulfatase whichis a lysosomal exohydrolase required for the degradation of theglycosaminoglycans, keratan sulfate, and chondroitin 6-sulfate.Sequence alterations including point, missense and nonsensemutations, as well as those that affect splicing, result in adeficiency of this enzyme. Deficiencies of this enzyme lead toMorquio A syndrome, a lysosomal storage disorder.
仅用于科研。不用于诊断过程。未经明确授权不得转售。
篇参考文献 (0)
生物信息学
蛋白别名: Chondroitinase; Chondroitinsulfatase; galactosamine (N-acetyl)-6-sulfate sulfatase; Galactose-6-sulfate sulfatase; GalN6S; GalNAc6S sulfatase; N-acetylgalactosamine-6-sulfatase; N-acetylgalactosamine-6-sulfate sulfatase; unnamed protein product
基因别名: GalN6S; GALNAC6S; GALNS; GAS; mFLJ00319; MPS4A
UniProt ID: (Human) P34059, (Mouse) Q571E4, (Rat) Q32KJ6
Entrez Gene ID: (Human) 2588, (Mouse) 50917, (Rat) 292073